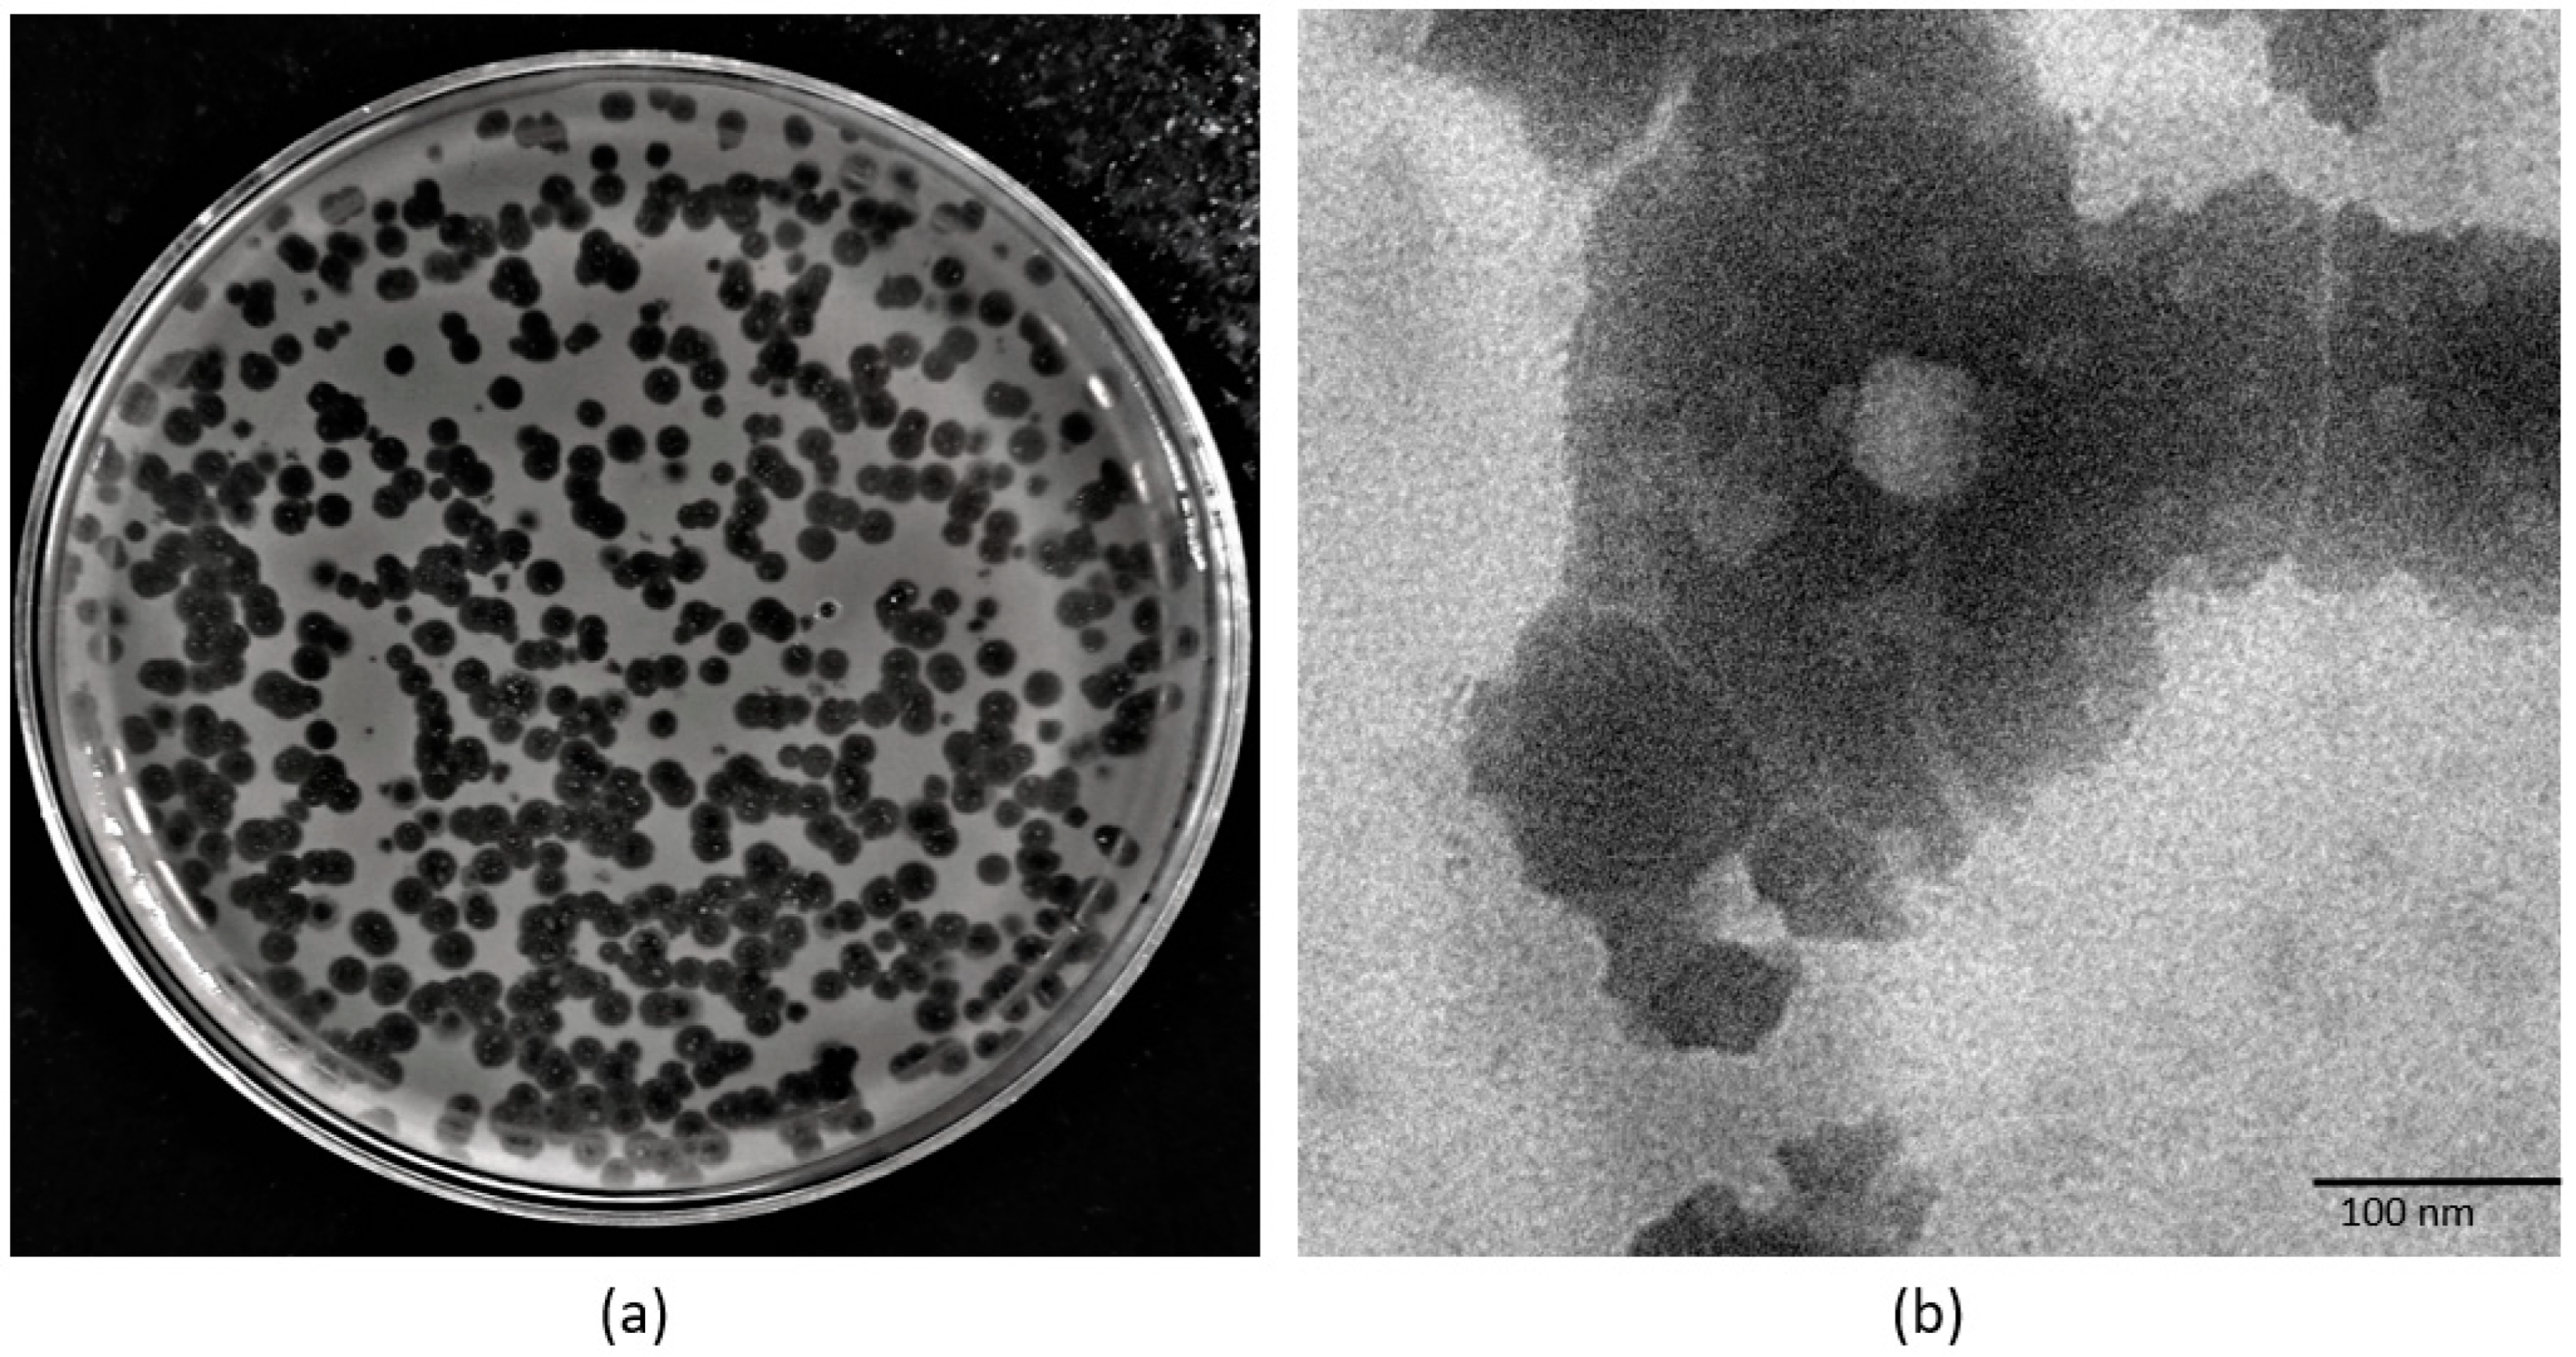
Pathogens 11 01448 g004 Pathogens 11 01448 g004

Genome Analysis and Antibiofilm Activity of Phage 590B against Multidrug-Resistant and Extensively Drug-Resistant Uropathogenic Escherichia coli Isolates, India
Abstract
1. Introduction
2. Materials and Methods
2.1. Sample Collection and Bacterial Strains Used
2.2. Phage Isolation and Purification
2.3. Phage Morphology
2.4. One-Step Growth Curve and Adsorption Assay
2.5. Phage Stability
2.6. Genomic DNA Extraction and Sequence Analysis
2.7. Phylogenetic Tree and Comparative Genomics
2.8. Anti-Biofilm Activity of the Phage
2.9. Infection of Disrupted Biofilms with Phage
2.10. Killing Efficiency of the Phage and Assessment of the Appearance of Phage-Resistant Bacteria
2.11. Nucleotide Sequence Accession Number
2.12. Statistical Analysis
3. Results
3.1. Phage Morphology, One-Step Growth Curve, and Adsorption Kinetics
3.2. Phage Stability
3.3. Genome of Escherichia Phage 590B
- (i)
- DNA replication and metabolism proteins: A total of 10 ORFs were predicted to encode for DNA replication and metabolism-related proteins such as HNH homing endonuclease, DNA helicase, putative C-specific methylase, VRR-NUC domain protein, DNA polymerase I, helix-destabilizing protein, nuclease superfamily protein, transcriptional repressor DicA, replicative helicase/primase, helix-turn-helix domain protein, and a transcriptional regulator.
- (ii)
- Structural and packaging proteins: Sixteen ORFs were predicted to encode for structural proteins such as portal protein, head protein, putative tail protein, a scaffold protein, putative major capsid protein, Ig-like domain-containing protein, head-to-tail connector complex protein, putative tail protein, tail protein, tail assembly chaperone, putative tape measure protein, minor tail protein, putative tail protein, tail_spike_N domain-containing protein, and 13.88 kDa late protein. ORF 1 and ORF 75 were predicted to encode for terminase large and small subunits, respectively.
- (iii)
- Host lysis and adhesion proteins: Four ORFs were predicted to encode for putative holins (class-I, II), endolysin, and putative spanin protein. BLASTP analysis of the Escherichia phage 590B genome revealed no similarities to genes encoding integrase, recombinase, or excisionase. As a result, phage 590B was classified as a virulent bacteriophage. Furthermore, no result was found against different databases such as VFDB (Virulence Factor Database), Virulence finder 2.0, PAIDB (Pathogenicity Island Database), CARD (Comprehensive Antibiotic Resistance Database), and CRISPRfinder. The genome of phage 590B revealed that it lacks genes encoding for toxins, virulence factors, antibiotic resistance, and CRISPR.
3.4. Phylogenetic Analysis and Comparative Genomics
3.5. Host Range Testing
3.6. Antibiofilm Activity of Phage 590B
- (i)
- Phage 590B activity against intact and disrupted biofilms formed on the Foley silicon catheter model.
- (ii)
- Phage activity against intact biofilm formed on polystyrene coverslip
3.7. Appearance of Phage-Resistant Bacteria in Planktonic Culture
4. Discussion
5. Conclusions
Supplementary Materials
Author Contributions
Funding
Institutional Review Board Statement
Informed Consent Statement
Data Availability Statement
Acknowledgments
Conflicts of Interest
References
- Saint, S.; Kowalski, C.P.; Kaufman, S.R.; Hofer, T.P.; Kauffman, C.A.; Olmsted, R.N.; Forman, J.; Banaszak-Holl, J.; Damschroder, L.; Krein, S.L. Preventing Hospital-Acquired Urinary Tract Infection in the United States: A National Study. Clin. Infect. Dis. 2008, 46, 243–250. [Google Scholar] [CrossRef] [PubMed]
- Terlizzi, M.E.; Gribaudo, G.; Maffei, M.E. UroPathogenic Escherichia Coli (UPEC) Infections: Virulence Factors, Bladder Responses, Antibiotic, and Non-Antibiotic Antimicrobial Strategies. Front. Microbiol. 2017, 8, 1566. [Google Scholar] [CrossRef]
- Mishra, M.P.; Sarangi, R.; Padhy, R.N. Prevalence of Multidrug-Resistant Uropathogenic Bacteria in Pediatric Patients of a Tertiary Care Hospital in Eastern India. J. Infect. Public Health 2016, 9, 308–314. [Google Scholar] [CrossRef] [PubMed]
- Trautner, B.W.; Darouiche, R.O. Role of Biofilm in Catheter-Associated Urinary Tract Infection. Am. J. Infect. Control 2004, 32, 177–183. [Google Scholar] [CrossRef] [PubMed]
- Hughes, K.A.; Sutherland, I.W.; Jones, M.V. Biofilm Susceptibility to Bacteriophage Attack: The Role of Phage-Borne Polysaccharide Depolymerase. Microbiology 1998, 144, 3039–3047. [Google Scholar] [CrossRef]
- Chan, B.; Abedon, S. Bacteriophages and Their Enzymes in Biofilm Control. Curr. Pharm. Des. 2014, 21, 85–99. [Google Scholar] [CrossRef]
- Ianiro, G.; Tilg, H.; Gasbarrini, A. Antibiotics as Deep Modulators of Gut Microbiota: Between Good and Evil. Gut 2016, 65, 1906–1915. [Google Scholar] [CrossRef]
- Bhardwaj, N.; Bhardwaj, S.K.; Deep, A.; Dahiya, S.K.S. Lytic Bacteriophages as Biocontrol Agents of Foodborne Pathogens. Asian J. Anim. Vet. Adv. 2015, 10, 708–723. [Google Scholar] [CrossRef]
- Magiorakos, A.P.; Srinivasan, A.; Carey, R.B.; Carmeli, Y.; Falagas, M.E.; Giske, C.G.; Harbarth, S.; Hindler, J.F.; Kahlmeter, G.; Olsson-Liljequist, B.; et al. Multidrug-Resistant, Extensively Drug-Resistant and Pandrug-Resistant Bacteria: An International Expert Proposal for Interim Standard Definitions for Acquired Resistance. Clin. Microbiol. Infect. 2012, 18, 268–281. [Google Scholar] [CrossRef]
- Chaudhary, N.; Mohan, B.; Mavuduru, R.S.; Kumar, Y.T.N. Characterization, Genome Analysis, and in Vitro Activity of a Novel Phage RDN8.1 Active Against Multi-Drug Resistant and Extensively Drug-Resistant Biofilm Forming Uropathogenic E. Coli Isolates, India. J. Appl. Microbiol. 2022, 132, 3387–3404. [Google Scholar] [CrossRef]
- Chaudhary, N.; Singh, D.; Maurya, R.K.; Mohan, B.; Taneja, N. Complete Genome Sequence of Salmonella Phage VB_SenA_SM5, Active against Multidrug-Resistant Salmonella Enterica Serovar Typhi Isolates. Microbiol. Resour. Announc. 2022, 44, e00309-22. [Google Scholar] [CrossRef] [PubMed]
- Surekhamol, I.S.; Deepa, G.D.; Somnath Pai, S.; Sreelakshmi, B.; Varghese, S.; Bright Singh, I.S. Isolation and Characterization of Broad Spectrum Bacteriophages Lytic to Vibrio Harveyi from Shrimp Farms of Kerala, India. Lett. Appl. Microbiol. 2014, 58, 197–204. [Google Scholar] [CrossRef] [PubMed]
- Liu, J.; Gao, S.; Dong, Y.; Lu, C.; Liu, Y. Isolation and Characterization of Bacteriophages against Virulent Aeromonas Hydrophila. BMC Microbiol. 2020, 20, 1–13. [Google Scholar] [CrossRef] [PubMed]
- Chen, L.; Yuan, S.; Liu, Q.; Mai, G.; Yang, J.; Deng, D. In Vitro Design and Evaluation of Phage Cocktails against Aeromonas Salmonicida. Front. Microbiol. 2018, 9, 1476. [Google Scholar] [CrossRef]
- Chaudhary, N.; Narayan, C.; Mohan, B.; Taneja, N. Characterization and in Vitro Activity of a Lytic Phage RDN37 Isolated from Community Sewage Water Active against MDR Uropathogenic E. Coli. Indian J. Med. Microbiol. 2021, 39, 343–348. [Google Scholar] [CrossRef]
- Chaudhary, N.; Singh, D.; Maurya, R.K.; Mohan, B.; Mavuduru, R.S.; Taneja, N. Whole Genome Sequencing and in vitro Activity Data of Escherichia Phage NTEC3 against Multidrug-Resistant Uropathogenic and Extensively Drug-Resistant Uropathogenic E. coli Isolates. Data Br. 2022, 43, 108479. [Google Scholar] [CrossRef] [PubMed]
- Hunt, M.; Gall, A.; Ong, S.H.; Brener, J.; Ferns, B.; Goulder, P.; Nastouli, E.; Keane, J.A.; Kellam, P.; Otto, T.D. IVA: Accurate de Novo Assembly of RNA Virus Genomes. Bioinformatics 2015, 31, 2374–2376. [Google Scholar] [CrossRef]
- Chaudhary, N.; Mohan, B.; Taneja, N. Draft Genome Sequence of Escherichia Phage PGN829.1, Active against Highly Drug-Resistant Uropathogenic Escherichia Coli. Microbiol. Resour. Announc. 2018, 7, 20. [Google Scholar] [CrossRef]
- Laslett, D.; Canback, B. ARAGORN, a Program to Detect TRNA Genes and TmRNA Genes in Nucleotide Sequences. Nucleic Acids Res. 2004, 32, 11–16. [Google Scholar] [CrossRef]
- Liu, B.; Zheng, D.; Jin, Q.; Chen, L.; Yang, J. VFDB 2019: A Comparative Pathogenomic Platform with an Interactive Web Interface. Nucleic Acids Res. 2019, 47, D687–D692. [Google Scholar] [CrossRef]
- Alcock, B.P.; Raphenya, A.R.; Lau, T.T.Y.; Tsang, K.K.; Bouchard, M.; Edalatmand, A.; Huynh, W.; Nguyen, A.L.V.; Cheng, A.A.; Liu, S.; et al. CARD 2020: Antibiotic Resistome Surveillance with the Comprehensive Antibiotic Resistance Database. Nucleic Acids Res. 2020, 48, D517–D525. [Google Scholar] [CrossRef] [PubMed]
- Couvin, D.; Bernheim, A.; Toffano-Nioche, C.; Touchon, M.; Michalik, J.; Néron, B.; Rocha, E.P.C.; Vergnaud, G.; Gautheret, D.; Pourcel, C. CRISPRCasFinder, an Update of CRISRFinder, Includes a Portable Version, Enhanced Performance and Integrates Search for Cas Proteins. Nucleic Acids Res. 2018, 46, W246–W251. [Google Scholar] [CrossRef] [PubMed]
- Kumar, S.; Stecher, G.; Li, M.; Knyaz, C.; Tamura, K. MEGA X: Molecular Evolutionary Genetics Analysis across Computing Platforms. Mol. Biol. Evol. 2018, 35, 1547–1549. [Google Scholar] [CrossRef]
- Darling, A.C.E.; Mau, B.; Blattner, F.R.; Perna, N.T. Mauve: Multiple Alignment of Conserved Genomic Sequence with Rearrangements. Genome Res. 2004, 14, 1394–1403. [Google Scholar] [CrossRef] [PubMed]
- Sullivan, M.J.; Petty, N.K.; Beatson, S.A. Easyfig: A Genome Comparison Visualizer. Bioinformatics 2011, 27, 1009–1010. [Google Scholar] [CrossRef] [PubMed]
- Turner, D.; Reynolds, D.; Seto, D.; Mahadevan, P. CoreGenes3.5: A Webserver for the Determination of Core Genes from Sets of Viral and Small Bacterial Genomes. BMC Res. Notes 2013, 6, 140. [Google Scholar] [CrossRef]
- Nishimura, Y.; Yoshida, T.; Kuronishi, M.; Uehara, H.; Ogata, H.; Goto, S. ViPTree: The Viral Proteomic Tree Server. Bioinformatics 2017, 33, 2379–2380. [Google Scholar] [CrossRef]
- Skurnik, M.; Jaakkola, S.; Mattinen, L.; von Ossowski, L.; Nawaz, A.; Pajunen, M.I.; Happonen, L.J. Bacteriophages Fev-1 and Fd1 Infect Yersinia Pestis. Viruses 2021, 13, 1384. [Google Scholar] [CrossRef]
- Kaur, H.; Kalia, M.; Chaudhary, N.; Singh, V.; Yadav, V.K.; Modgil, V.; Kant, V.; Mohan, B.; Bhatia, A.T. Repurposing of FDA Approved Drugs against Uropathogenic Escherichia Coli: In Silico, In Vitro, and In Vivo Analysis. Microb. Pathog. 2022, 169, 105665. [Google Scholar] [CrossRef]
- O’Toole, G.A.; Kolter, R. Flagellar and Twitching Motility Are Necessary for Pseudomonas Aeruginosa Biofilm Development. Mol. Microbiol. 1998, 30, 295–304. [Google Scholar] [CrossRef]
- Tzipilevich, E.; Pollak-Fiyaksel, O.; Shraiteh, B.-Y.S. Bacteria Elicit a Phage Tolerance Response Subsequent to Infection of Their Neighbors. EMBO J. 2022, 41, e109247. [Google Scholar] [CrossRef] [PubMed]
- Römling, U.; Balsalobre, C. Biofilm Infections, Their Resilience to Therapy and Innovative Treatment Strategies. J. Intern. Med. 2012, 272, 541–561. [Google Scholar] [CrossRef] [PubMed]
- Tenke, P.; Kovacs, B.; Jäckel, M.; Nagy, E. The Role of Biofilm Infection in Urology. World J. Urol. 2006, 24, 13. [Google Scholar] [CrossRef]
- Choong, S.; Whitfield, H. Biofilms and Their Role in Infections in Urology. BJU Int. 2000, 86, 935–941. [Google Scholar] [CrossRef]
- Nickel, J.C.; Ruseska, I.; Wright, J.B.; Costerton, J.W. Tobramycin Resistance of Pseudomonas Aeruginosa Cells Growing as a Biofilm on Urinary Catheter Material. Antimicrob. Agents Chemother. 1985, 27, 619–624. [Google Scholar] [CrossRef] [PubMed]
- Tambyah, P.A. Catheter-Associated Urinary Tract Infections: Diagnosis and Prophylaxis. Int. J. Antimicrob. Agents 2004, 1, 44–48. [Google Scholar] [CrossRef] [PubMed]
- Lin, D.M.; Koskella, B.; Lin, H.C. Phage Therapy: An Alternative to Antibiotics in the Age of Multi-Drug Resistance. World J. Gastrointest. Pharmacol. Ther. 2017, 8, 162–173. [Google Scholar] [CrossRef]
- Zalewska-Piątek, B.; Piątek, R. Phage Therapy as a Novel Strategy in the Treatment of Urinary Tract Infections Caused by e. Coli. Antibiotics 2020, 9, 304. [Google Scholar] [CrossRef]
- Hosseinidoust, Z.; Tufenkji, N.; van de Ven, T.G.M. Formation of Biofilms under Phage Predation: Considerations Concerning a Biofilm Increase. Biofouling 2013, 29, 457–468. [Google Scholar] [CrossRef]
- Pires, D.P.; Melo, L.D.R.; Vilas Boas, D.; Sillankorva, S.; Azeredo, J. Phage Therapy as an Alternative or Complementary Strategy to Prevent and Control Biofilm-Related Infections. Curr. Opin. Microbiol. 2017, 39, 48–56. [Google Scholar] [CrossRef]
- Sillankorva, S.; Oliveira, R.; Vieira, M.J.; Sutherland, I.W.; Azeredo, J. Bacteriophage Φ S1 Infection of Pseudomonas Fluorescens Planktonic Cells versus Biofilms. Biofouling 2004, 20, 133–138. [Google Scholar] [CrossRef]
- Hu, J.; Miyanaga, K.; Tanji, Y. Diffusion Properties of Bacteriophages through Agarose Gel Membrane. Biotechnol. Prog. 2010, 26, 1213–1221. [Google Scholar] [CrossRef] [PubMed]
- Chibeu, A.; Lingohr, E.J.; Masson, L.; Manges, A.; Harel, J.; Ackermann, H.-W.; Kropinski, A.M.; Boerlin, P. Bacteriophages with the Ability to Degrade Uropathogenic. Viruses 2012, 4, 471–487. [Google Scholar] [CrossRef] [PubMed]
- Ackermann, H.W. Tailed Bacteriophages: The Order Caudovirales. Adv. Virus Res. 1998, 51, 135–201. [Google Scholar] [CrossRef] [PubMed]
- Schmelcher, M.; Donovan, D.M.; Loessner, M.J. Bacteriophage Endolysins as Novel Antimicrobials. Future Microbiol. 2012, 7, 1147–1171. [Google Scholar] [CrossRef]
- Murray, E.; Draper, L.A.; Ross, R.P.; Hill, C. The Advantages and Challenges of Using Endolysins in a Clinical Setting. Viruses 2021, 13, 680. [Google Scholar] [CrossRef]
- Haddad Kashani, H.; Schmelcher, M.; Sabzalipoor, H.; Seyed Hosseini, E.; Moniri, R. Recombinant Endolysins as Potential Therapeutics against Antibiotic-Resistant Staphylococcus Aureus: Current Status of Research and Novel Delivery Strategies. Clin. Microbiol. Rev. 2018, 31, e00071-17. [Google Scholar] [CrossRef]
- Roach, D.R.; Donovan, D.M. Antimicrobial Bacteriophage-Derived Proteins and Therapeutic Applications. Bacteriophage 2015, 5, e1062590. [Google Scholar] [CrossRef]
- Li, N.; Zeng, Y.; Wang, M.; Bao, R.; Chen, Y.; Li, X.; Pan, J.; Zhu, T.; Hu, B.; Tan, D. Characterization of Phage Resistance and Their Impacts on Bacterial Fitness in Pseudomonas Aeruginosa. Microbiol. Spectr. 2022, 10, e02072-22. [Google Scholar] [CrossRef]
- Huang, C.; Virk, S.M.; Shi, J.; Zhou, Y.; Willias, S.P.; Morsy, M.K.; Abdelnabby, H.E.; Liu, J.; Wang, X.; Li, J. Isolation, Characterization, and Application of Bacteriophage LPSE1 against Salmonella Enterica in Ready to Eat (RTE) Foods. Front. Microbiol. 2018, 9, 1046. [Google Scholar] [CrossRef]
- Gu, Y.; Xu, Y.; Xu, J.; Yu, X.; Huang, X.; Liu, G.; Liu, X. Identification of Novel Bacteriophage vB_EcoP-EG1 with Lytic Activity against Planktonic and Biofilm Forms of Uropathogenic Escherichia Coli. Appl. Microbiol. Biotechnol. 2018, 103, 315–326. [Google Scholar] [CrossRef] [PubMed]
- Dalmasso, M.; Strain, R.; Neve, H.; Franz, C.M.A.P.; Cousin, F.J.; Ross, R.P.; Hill, C. Three New Escherichia Coli Phages from the Human Gut Show Promising Potential for Phage Therapy. PLoS ONE 2016, 11, e0156773. [Google Scholar] [CrossRef] [PubMed]
- Topka-Bielecka, G.; Nejman-Faleńczyk, B.; Bloch, S.; Dydecka, A.; Necel, A.; Węgrzyn, A.; Węgrzyn, G. Phage–Bacteria Interactions in Potential Applications of Bacteriophage Vb_efas-271 against Enterococcus Faecalis. Viruses 2021, 13, 318. [Google Scholar] [CrossRef]
- Gurney, J.; Pradier, L.; Griffin, J.S.; Gougat-Barbera, C.; Chan, B.K.; Turner, P.E.; Kaltz, O.; Hochberg, M.E. Phage Steering of Antibiotic-Resistance Evolution in the Bacterial Pathogen, Pseudomonas Aeruginosa. Evol. Med. Public Heal. 2020, 2020, 148–157. [Google Scholar] [CrossRef]
- Yıldirim, Z.; Sakin, T.; Akçelik, M.; Akçelik, N. Identification and Characterization of Lytic Bacteriophages Specific to Foodborne Pathogenic Escherichia coli O157:H7. Food Sci. Technol. Int. 2021, 27, 56–72. [Google Scholar] [CrossRef] [PubMed]
- Litt, P.K.; Jaroni, D. Isolation and Physiomorphological Characterization of Escherichia Coli O157:H7-Infecting Bacteriophages Recovered from Beef Cattle Operations. Int. J. Microbiol. 2017, 2017, 7013236. [Google Scholar] [CrossRef] [PubMed]
- Yazdi, M.; Bouzari, M.; Ghaemi, E.A.; Shahin, K. Isolation, Characterization and Genomic Analysis of a Novel Bacteriophage VB_EcoS-Golestan Infecting Multidrug-Resistant Escherichia Coli Isolated from Urinary Tract Infection. Sci. Rep. 2020, 10, 7690. [Google Scholar] [CrossRef]

| Phage Name | Taxonomic Genus | Isolation Year | Isolation Source | Genomic Size (bp) | No. of ORFs | Genbank Accession Number |
|---|---|---|---|---|---|---|
| Escherichia phage vB_EcoS_XY2 | Kagunavirus | 2020 | Sewage water | 44138 | 73 | MN927226 |
| Escherichia phage VB_EcoS-Golestan | Kagunavirus | 2020 | Sewage water | 44829 | 78 | MG099933 |
| Escherichia phage phiWAO78-1 | Kagunavirus | 2021 | Sewage water | 44551 | 83 | MW331437 |
| Escherichia phage NTEC3 | Kagunavirus | 2021 | Sewage water | 44240 | 74 | OK539620 |
| Escherichia phage 590B | Kagunavirus | 2021 | Sewage water | 44390 | 52 | MW722821 |
| UPEC 590B Variants | Phage Sensitivity | Plaque Morphology | % Phage Adsorption | Biofilm Formation (OD595) |
|---|---|---|---|---|
| V1 | - | NP | 7 ± 0.2 | 1.203 ± 0.04 |
| V2 | - | NP | 10 ± 0.5 | 0.315 ± 0.07 |
| V3 | + | NP | 25 ± 1 | 0.503 ± 0.0.01 |
| V4 | - | NP | 12 ± 1 | 0.405 ± 0.03 |
| V5 | - | NP | 10 ± 0.5 | 0.301 ± 0.04 |
| V6 | - | NP | 6 ± 0.5 | 0.410 ± 0.08 |
| V7 | - | NP | 10 ± 0.4 | 0.308 ± 0.06 |
| V8 | - | NP | 4 ± 0.2 | 0.405 ± 0.04 |
| V9 | - | NP | 8 ± 0.5 | 0.400 ± 0.08 |
| V10 | - | NP | 4 ± 0.2 | 0.402 ± 0.04 |
Publisher’s Note: MDPI stays neutral with regard to jurisdictional claims in published maps and institutional affiliations. |
© 2022 by the authors. Licensee MDPI, Basel, Switzerland. This article is an open access article distributed under the terms and conditions of the Creative Commons Attribution (CC BY) license (https://creativecommons.org/licenses/by/4.0/).
Share and Cite
Chaudhary, N.; Maurya, R.K.; Singh, D.; Mohan, B.; Taneja, N. Genome Analysis and Antibiofilm Activity of Phage 590B against Multidrug-Resistant and Extensively Drug-Resistant Uropathogenic Escherichia coli Isolates, India. Pathogens 2022, 11, 1448. https://doi.org/10.3390/pathogens11121448
Chaudhary N, Maurya RK, Singh D, Mohan B, Taneja N. Genome Analysis and Antibiofilm Activity of Phage 590B against Multidrug-Resistant and Extensively Drug-Resistant Uropathogenic Escherichia coli Isolates, India. Pathogens. 2022; 11(12):1448. https://doi.org/10.3390/pathogens11121448
Chicago/Turabian StyleChaudhary, Naveen, Ravi Kumar Maurya, Dharminder Singh, Balvinder Mohan, and Neelam Taneja. 2022. "Genome Analysis and Antibiofilm Activity of Phage 590B against Multidrug-Resistant and Extensively Drug-Resistant Uropathogenic Escherichia coli Isolates, India" Pathogens 11, no. 12: 1448. https://doi.org/10.3390/pathogens11121448
APA StyleChaudhary, N., Maurya, R. K., Singh, D., Mohan, B., & Taneja, N. (2022). Genome Analysis and Antibiofilm Activity of Phage 590B against Multidrug-Resistant and Extensively Drug-Resistant Uropathogenic Escherichia coli Isolates, India. Pathogens, 11(12), 1448. https://doi.org/10.3390/pathogens11121448
